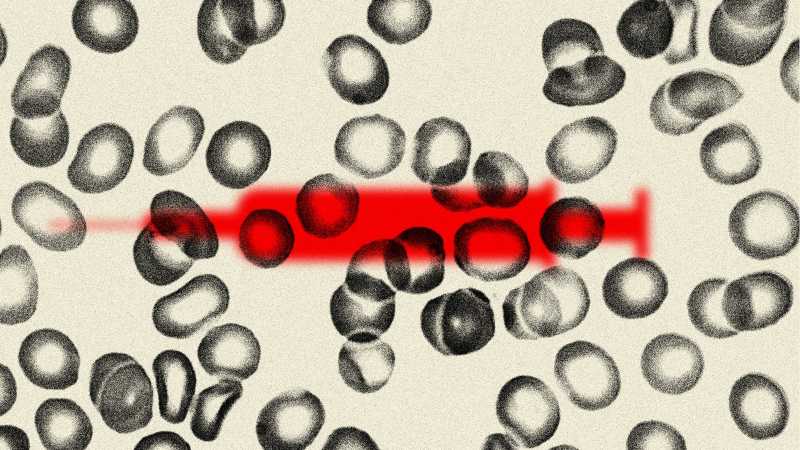

Czy powinniśmy mieć prawo odmówić transfuzji krwi od osób zaszczepionych na COVID-19? A co z narządami oddanymi przez zaszczepionych? W większości krajów każdy zaszczepiony na COVID-19 może oddać krew natychmiast lub wkrótce po zaszczepieniu, mimo że ten produkt eksperymentalny może wywoływać zagrażające życiu zaburzenia u biorców.
−∗−
W menu na dziś danie przypominające. Artykuł z czerwca zeszłego roku, ale problem wciąż aktualny, mianowicie co dalej z transfuzjami krwi i przeszczepami organów? Czy biorca jest bezpieczny? Czy krew można oddawać tuż po szczepieniu, a może należy odczekać jakiś czas? Te kwestie nie goszczą w nagłówkach mediów głównego nurtu.
Zapraszam do lektury.
____________***____________
Zaszczepiona krew – dylemat covidowych transfuzji eksperymentalnych
Czy powinniśmy mieć prawo odmówić transfuzji krwi od osób zaszczepionych na COVID-19? A co z narządami oddanymi przez zaszczepionych?
W większości krajów każdy zaszczepiony na COVID-19 może oddać krew natychmiast lub wkrótce po zaszczepieniu, mimo że ten produkt eksperymentalny może wywoływać zagrażające życiu zaburzenia u biorców.
Krew od dawcy zmiesza się z twoją, a budzące niepokój białko kolczaste, wstrzyknięte z krwią dawcy, będzie krążyć i łączyć się z twoim ciałem.
Zdecydowana większość ludzi, zwłaszcza media, nie zajmuje się tym problemem. Zainteresowani obywatele powinni pisać do wszystkich organów służby zdrowia, polityków i instytucji zdrowia publicznego oraz żądać badań przesiewowych i oddzielnych banków krwi oraz wyraźnej identyfikacji krwi osób zaszczepionych i niezaszczepionych. Nikt nie zna długoterminowych danych dotyczących bezpieczeństwa. To globalny eksperyment na ludzkości i trzeba go powstrzymać!
Obejrzyj poniższy film, aby zapoznać się z poziomem zagrożenia:
Czy ktoś jeszcze pamięta upadek pandemii AIDS, kiedy oddawano zarażoną krew, która zniszczyła życie tysięcy ludzi?
Pod koniec lat 70. i na początku 80. osoby cierpiące na hemofilię w Wielkiej Brytanii, cierpiące na zaburzenia krzepnięcia krwi, otrzymywały krew oddaną lub sprzedaną przez osoby zakażone wirusem HIV i wirusowym zapaleniem wątroby typu C.
Według dziennika The Guardian (z 11 lipca 2017r.) osoby z hemofilią domagały się odszkodowania po tym jak:
„4800 z nich zostało zarażonych wirusem zapalenia wątroby typu C, który powoduje uszkodzenie wątroby i może być śmiertelny. Spośród nich 1200 było również zarażonych wirusem HIV, który może powodować AIDS. Połowa – 2400 – do teraz zmarła”.
W 1991 roku, kiedy działacze zagrozili, że podadzą rząd do sądu, ten wypłacił świadczenia ex-gratia [kulancja -tłum.] osobom zarażonym wirusem HIV, średnio po 60 000 funtów na głowę, pod warunkiem, że zrezygnują z dalszych roszczeń prawnych. Rozmiary zakażenia wirusem zapalenia wątroby typu C odkryto dopiero po latach.
Dzisiaj, kiedy eksperymentalne szczepionki przeciw COVID-19 są obwiniane za ponad milion przypadków powikłań, możemy być pewni, że ta historia jest kolejną tykającą bombą zegarową w rządowej porażce.
________________
Uzupełnienia:
Największy eksperyment w dziejach
Mówiąc najprościej, ani osoby podające szczepionki, ani osoby je otrzymujące nie mogą mieć pojęcia o potencjalnych średnio- i długoterminowych konsekwencjach tych rzeczy, ponieważ firmy je produkujące nie ukończyły badań nad […]
________________
Dno DNA czyli Homo Sapiens GMO
Twój paszport do Nowego Wspaniałego Świata. Jesteś „odporny”, więc możesz wyjść z trybu strachu. I krążyć, podróżować i wchodzić do szkół… (…) niektórzy ludzie mogą obawiać się strategii szczepień, która […]
________________
Czy chcą nas zabić?
Co do kampanii masowych szczepień, jest to najbardziej maniakalnie ludobójczy projekt, jaki kiedykolwiek wymyślił człowiek. Po prostu nie ma sposobu, aby obliczyć ilość cierpienia i śmierci, z jaką przyjdzie nam […]
________________
„Nigdy w historii medycyny…”
Sekcje zostały wykonane na formalną prośbę rodzin. Na dziesięć zgonów siedem jest „prawdopodobnie” związanych ze szczepieniami, z których pięć jest związanych „bardzo prawdopodobnie”. Z trzech pozostałych przypadków jeden pozostaje do […]
Oczywiście nie jest to jedyny temat, którym nie interesują się główne media, a który gdzieś żyje swoim życiem ‘w tle’.
W kwestiach międzynarodowych np:
Międzynarodowy traktat w sprawie profilaktyki i gotowości pandemicznej
A na krajowym ‘podwórku’ coś bardziej przyziemnego:
Pustostany czyli samo zło
_______________
Obostrzenia pandemiczne może i są redukowane, ale sama ‘pandemia’ i dodatkowe ‘atrakcje’ nie znikają.
…nie tylko krew…
Temat wrócił, bo musiał. Wcześniej czy później.
_________________
Ludzie nie chcą krwi od zaszczepionych dawców, 19.04.2026
Obce białko w postaci krwi, jej składników ZAWSZE jest związane z ryzykiem wczesnej oraz późnej reakcji poprzetoczeniowej. Opowiadanie o istnieniu “bliźniaków genetycznych”, zgodności “grup krwi” należy do bajek medycznych. Mity te upadają po wczytaniu się w OPISY, INSTRUKCJE PRAKTYCZNE dotyczące przetaczania krwi.
I nie ma znaczenia, czy pochodzi ona od człowieka szczepionego, czy nie. KAŻDY element BIOLOGICZNY organizmu związany z mnożeniem komórek (krwi czy innych)podlega PRAWOM BIOLOGICZNYM. A podstawą BOSKIEJ ORGANIZACJI ŻYCIA jest ORYGINALNOŚĆ I NIEPOWTARZALNOŚĆ każdego stworzenia.
Coraz trudniej dotrzeć w sieci do INSTRUKCJI specjalistycznych- medycznych, trzeba logować się jako medyk albo płacić. W przestrzeń darmochy informacyjnej wkracza usłużna AI, gdzie wszystko “gra i koliduje”.
Ale np. TU
Znaleźć można DEFINICJE pojęć związanych z przetaczaniem krwi oraz zagrożenia :
Ważna uwaga:
Jest tez TABELA, którą warto obejrzeć i SPRAWDZIĆ definicje pojęć np Alloimmunizacja to proces wytwarzania przez układ odpornościowy przeciwciał przeciwko obcym antygenom pochodzącym od innej osoby z tego samego gatunku. Występuje najczęściej po transfuzji krwi, w ciąży lub po przeszczepie. Może prowadzić do powikłań poprzetoczeniowych, konfliktu serologicznego (np. Rh) lub małopłytkowości.
Na potrzeby geszeftu “leczenia” białaczek “przeszczepami” krwi rzekomo od “biologicznych bliźniaków” powstały pojęcia “przeszczep przeciwko gospdarzowi”. To jest tak absurdalna hucpa pojęciowa, która reakcje uczulenia na OBCE BIAŁKO KRWI utożsamia z wyrzucaniem gospodarza z własnego domu przez “gościa”.
Przetaczanie rzekomo szpiku jest zwykłym przetaczaniem krwi, obciążonym ryzykiem opisanym w źródle.
Ale krwiożerczy geszeft organizacji pasozytku publicznego “sze kręczy” z efektami statystycznymi. Dzieci u których szamani medyczni diagnozują białaczki zostają poddawane fakrmakologicznej powolnej eutanazji a przetaczanie krwi od nieistniejącego bliźniaka jest dodatkowym truciem organizmu.
Konflikt biologiczny Faza aktywna konfliktu Faza uzdrawiania
Anemia i białaczka
https://learninggnm.com/SBS/documents/bones.html
Odpowiedzi na pytanie DLACZEGO jest to najczęstszy nowotwór dzieci, każdy powinien udzielić sobie sam.
Przegląd od AI
Białaczka to najczęstszy nowotwór u dzieci w Polsce, stanowiący ok. 30% przypadków onkologicznych u dzieci. Rocznie diagnozuje się ok. 200–300 nowych zachorowań, najczęściej między 2. a 5. rokiem życia. Dzięki nowoczesnym terapiom (np. CAR-T), wyleczalność ostrej białaczki limfoblastycznej (ALL) przekracza 90%, co stawia Polskę w czołówce Europy.
===
Co do rzekomej skuteczności, cytat z https://www.termedia.pl/mz/Badanie-przyczyn-roznorodnej-odpowiedzi-na-leczenie-CAR-T,60810.html
“pomimo dużej skuteczności terapii CAR-T wciąż stosunkowo wysoki odsetek pacjentów nie uzyskuje odpowiedzi na leczenie. Ponadto terapia CAR-T wiąże się z poważnymi działaniami niepożądanymi, takimi jak zespół uwalniania cytokin (ang. cytokine release syndrome, CRS), neurotoksyczność oraz przetrwałe zaburzenia morfologii krwi. Do tej pory nie ustalono przyczyn stojących za różnorodnością odpowiedzi na leczenie oraz skłonnością pacjentów do zdarzeń niepożądanych.”
Statystyk przeżycia białaczki u dzieci – nie ma danych
Ale są dane wiele mówiące w linku
https://upacjenta.pl/poradnik/bialaczka-objawy-wyniki-krwi
“Długość życia z przewlekłą białaczką limfatyczną (CLL) to według szacunków nawet 10 lat – o ile pacjent dobrze reaguje na leczenie.”
Drugi “obiecujący” cytat:
“Długość życia z ostrą białaczką limfoblastyczną (ALL) jest również bardzo obiecująca:
u chorych remisję choroby uzyskuje się w 70–90% przypadków, zależnie od intensywności leczenia i podtypu leukemii. Natomiast odsetek 5-letnich przeżyć u chorych z ALL wynosi 45–50%.”
Medycyna Lucyfera w demonicznej okazałości.
Kiedy ja studiowałam choroby takie jak białaczka i gruźlica były leczone DIETĄ wysokobiałkową i leżakowaniem na słońcu na świeżym powietrzu.